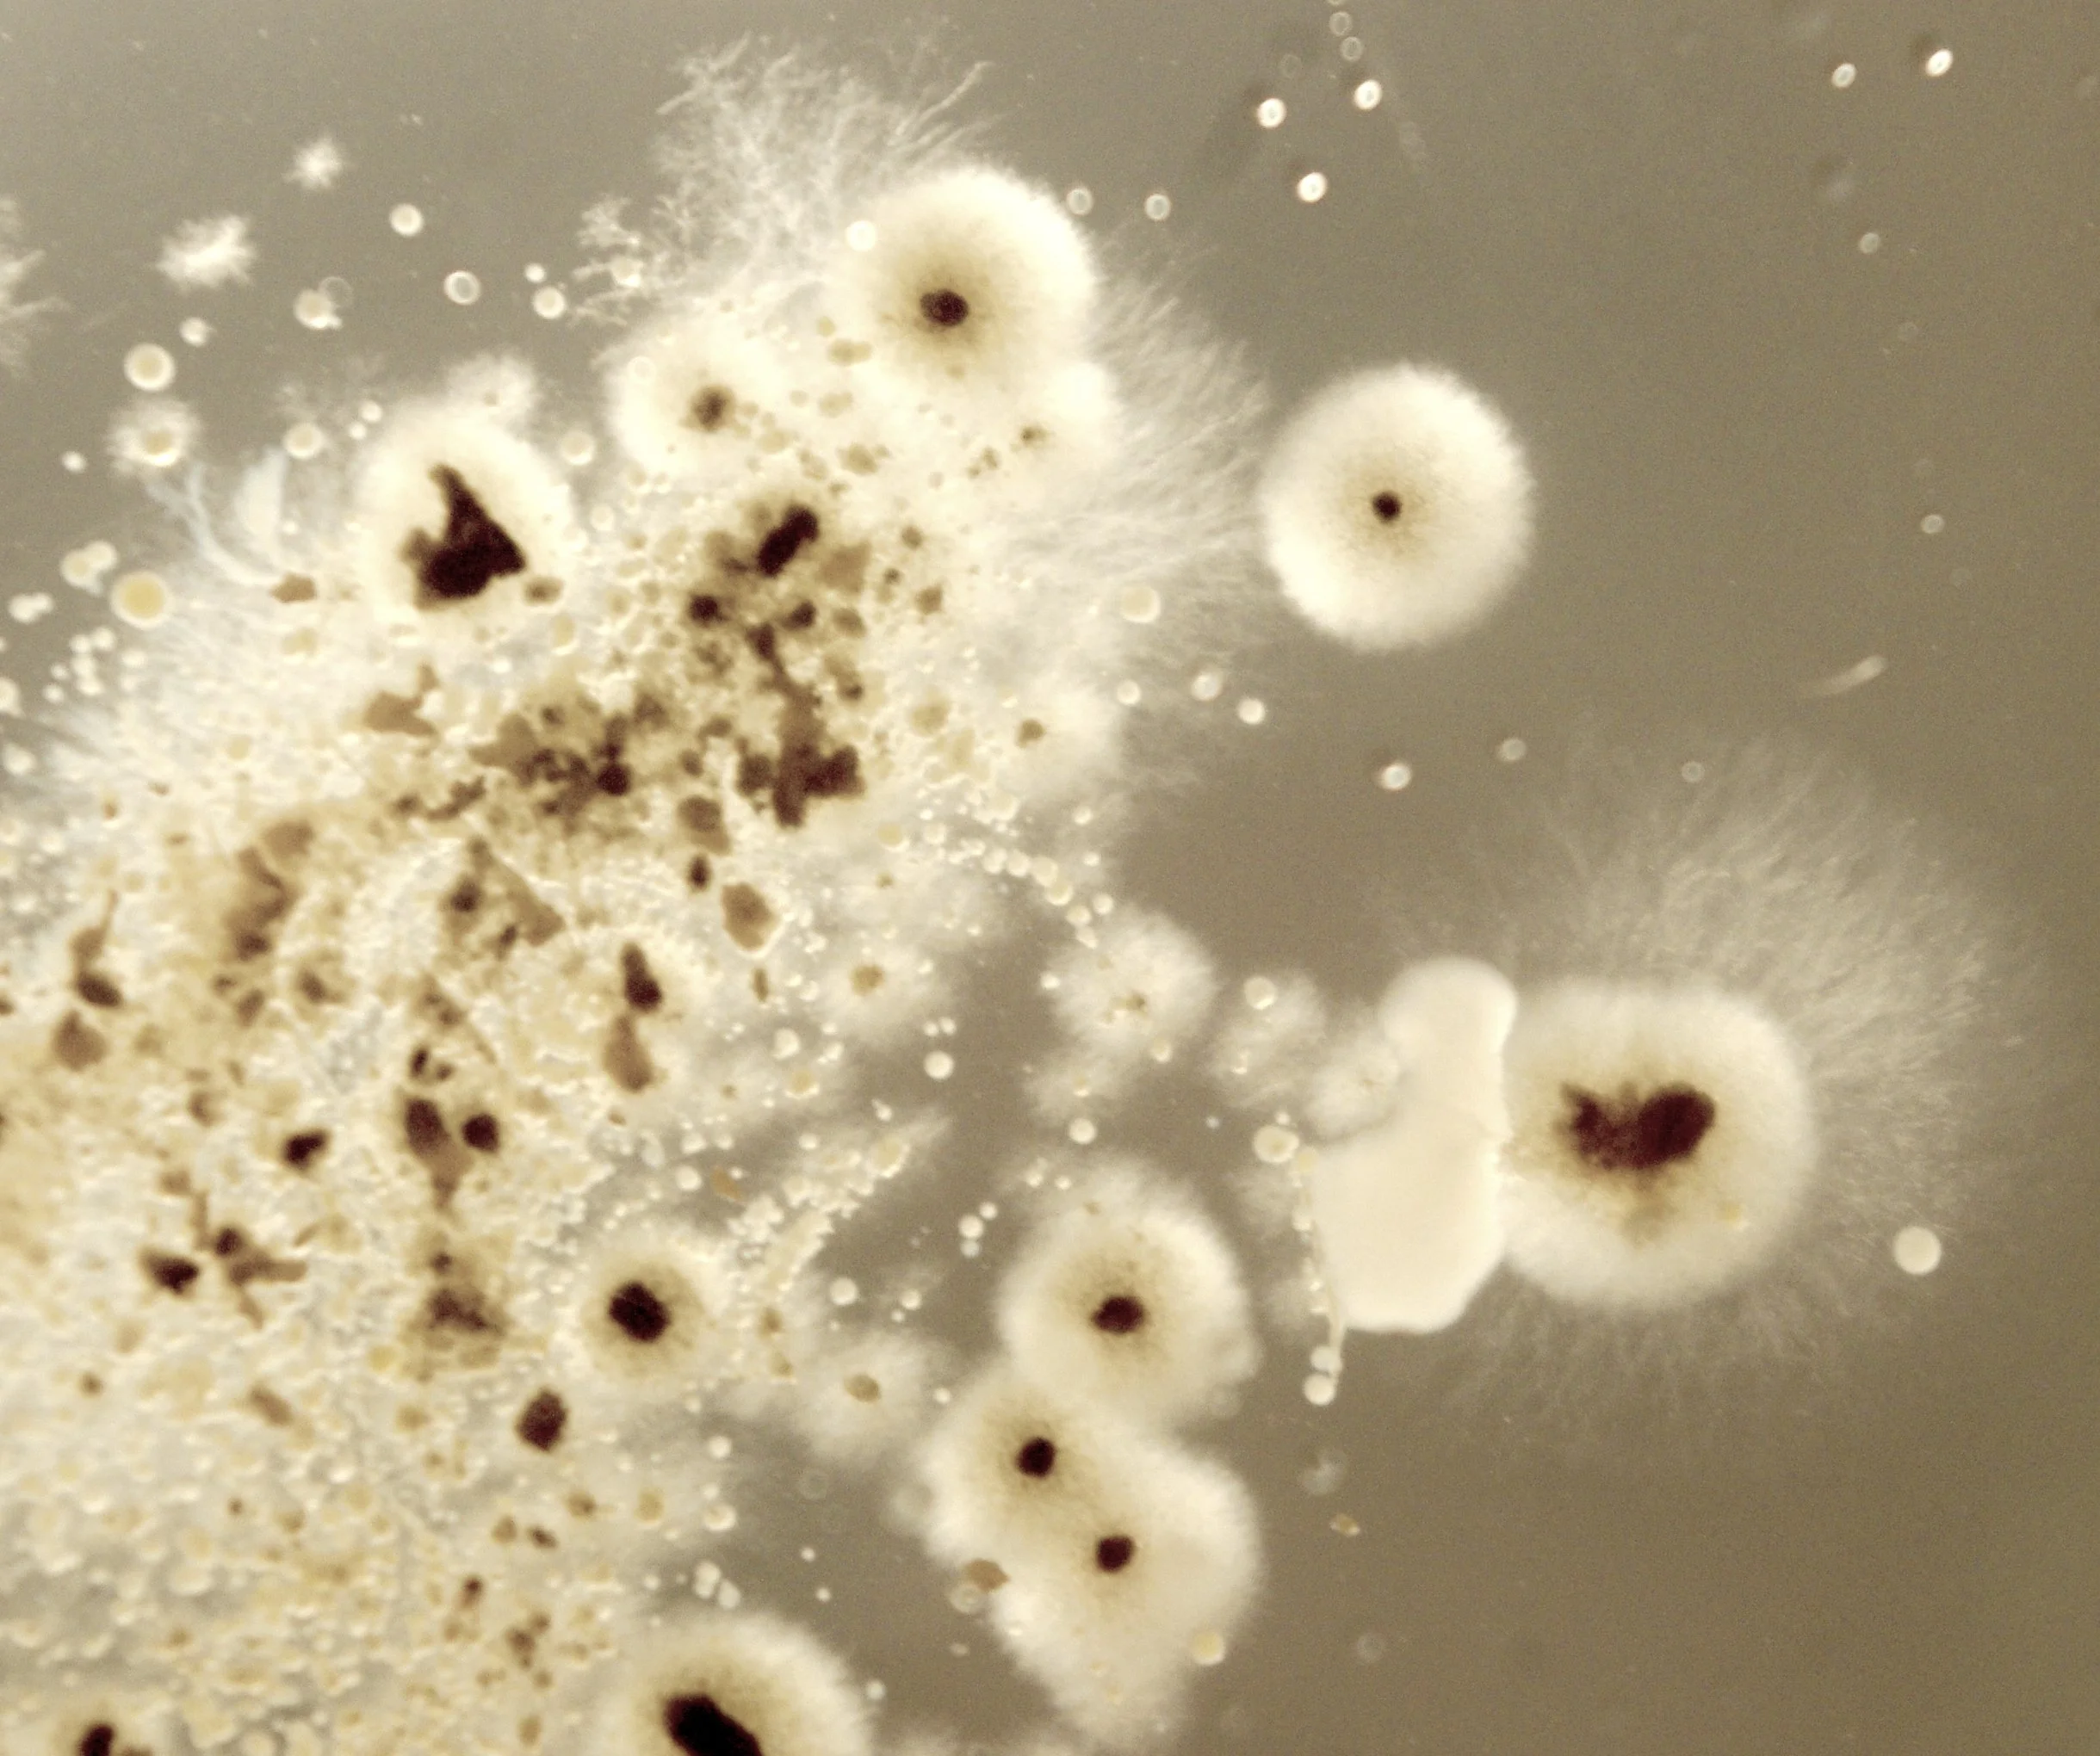

Our Services…
We provide several inspection services including Home Inspections, Mold Inspections, Mold Testing, Thermal Imaging, Radon Testing, Gas Leak Detection, Borescope Inspections, and Indoor Air Quality (IAQ) Testing. We can also “group” any services you may desire, allowing for ease of scheduling if you require any add-ons or ancillary inspections. All inspections will result in a final report which is sent to you within one business day following your inspection. For Mold Inspections that include lab testing, a second email with lab results will be sent when we recieve your results. We offer Air Sampling (spore trap) and Surface Sampling (swab or tape) for Mold Testing.

Home Inspection Service
Our comprehensive home inspection provides a detailed evaluation of a property's major systems and components, including the roof, foundation, plumbing, electrical, HVAC, and more. Designed to give buyers, sellers, and homeowners peace of mind, our inspections identify safety concerns, maintenance issues, and potential future repairs… empowering you to make informed decisions with confidence.

Radon Testing Service
Our radon testing service measures the levels of radon gas in your home—a naturally occurring, odorless radioactive gas that can pose serious health risks over time. Using professional-grade equipment, we provide accurate results to help ensure your indoor air is safe. Recommended for all homeowners and especially critical during real estate transactions.

Particle ID Indoor Air Quality Testing
Enhance your inspection with additional indoor air quality (IAQ) testing to detect pollutants such as mold spores, allergens, soot, smoke, and other airborne contaminants. Ideal for homes with health concerns, musty odors, or recent water damage. Lab results provide a clearer picture of your home’s air quality and are delivered within 2–4 business days. Standalone testing also available
Gas Leak Detection
Our gas leak detection service uses specialized equipment to identify the presence of natural gas or propane leaks in and around your home. This non-invasive service helps ensure the safety of your household by detecting even small leaks that may go unnoticed. It can be added to a home inspection or scheduled as a standalone service for peace of mind. Early detection helps prevent health hazards, fire risks, and costly repairs.
Mold Inspection Service
Our mold inspection service identifies signs of mold growth, moisture intrusion, and potential air quality issues in your home or property. Our laboratory results are typically made available 24 hours after samples are collected. Using advanced tools and, when necessary, lab testing, we assess both visible and hidden problem areas to help protect your health and property value. Ideal for homeowners, buyers, or anyone concerned about indoor air quality.

Additional Mold Testing (Add-On)
This optional service includes extra air or surface samples taken during your mold inspection to further assess the extent and type of mold present. Ideal for larger properties, multiple areas of concern, or when lab confirmation is needed beyond the standard inspection. Results are lab-analyzed and are typically delivered within 1 business day.

Thermal Imaging Service
Our thermal imaging service uses infrared technology to detect hidden issues in your home that aren’t visible to the naked eye. It helps identify overheating electrical components, moisture intrusion, and air leaks… pinpointing problem areas behind walls, ceilings, and floors. This non-invasive inspection adds an extra layer of insight for energy efficiency, safety, and preventive maintenance.
Borescope Inspection
A borescope inspection allows us to visually examine areas that are otherwise hidden or difficult to access, such as behind walls, inside ductwork, or within crawlspaces. Used when specific concerns arise, this service helps identify potential issues like hidden moisture, pests, or structural problems without invasive demolition. Ideal for targeted problem areas.
Regardless of what you may need… We look forward to serving you!
Home Inspections near you Home Inspections near me Home Inspections Northern Colorado Home Inspections NOCO Home Inspections Fort Collins Home Inspections Colorado Home Inspections Affordable Affordable Home Inspections Home Inspector near you Home Inspector near me Home Inspector Northern Colorado Home Inspector NOCO Home Inspector Fort Collins Home Inspector Colorado Home Inspector Affordable Affordable Home Inspector Colorado Home Inspector Colorado Home Inspectors Affordable Home Inspectors Home Inspectors Affordable Best Home Inspector Colorado Best Home Inspections Colorado Best Home Inspectors Colorado Best Home Inspectors Best Home Inspections Affordable Home Inspectors Affordable Home Inspections Home Inspection Information Information about Home Inspections Mold Inspections near you Mold Inspections near me Mold Inspections Northern Colorado Mold Inspections NOCO Mold Inspections Fort Collins Mold Inspections Colorado Mold Inspections Affordable Affordable Mold Inspections Mold Inspectors near you Mold Inspectors near me Mold Inspectors Northern Colorado Mold Inspectors NOCO Mold Inspectors Fort Collins Mold Inspectors Colorado Mold Inspectors Affordable Affordable Mold Inspectors Mold Testing near you Mold Testing near me Mold Testing Northern Colorado Mold Testing NOCO Mold Testing Fort Collins Mold Testing Colorado Mold Testing Affordable Affordable Mold Testing Mold Inspectors Boulder Mold Inspections Boulder Mold Testing Boulder Mold Test Boulder Mold Test near me Mold Test Northern Colorado Mold Test NOCO Mold Test Fort Collins Mold Test Colorado Mold Test Affordable Affordable Mold Tests Affordable Mold Test Mold Inspection Information Information about Mold Inspections Radon Testing near you Radon Testing near me Radon Testing Northern Colorado Radon Testing NOCO Radon Testing Fort Collins Radon Testing Colorado Radon Testing Affordable Affordable Radon Testing Radon Testing Boulder Radon
Moisture Damage Mitigation Reports
Have you experienced plumbing leaks, burst pipes, roof leaks, or other water damage related issues in your home or property? Are you having trouble with your homeowner’s insurance not paying for repairs? Then this service is for you! We offer moisture damage mitigation reports that assist with real estate transactions as well as proving to insurance that the problem was fixed.
